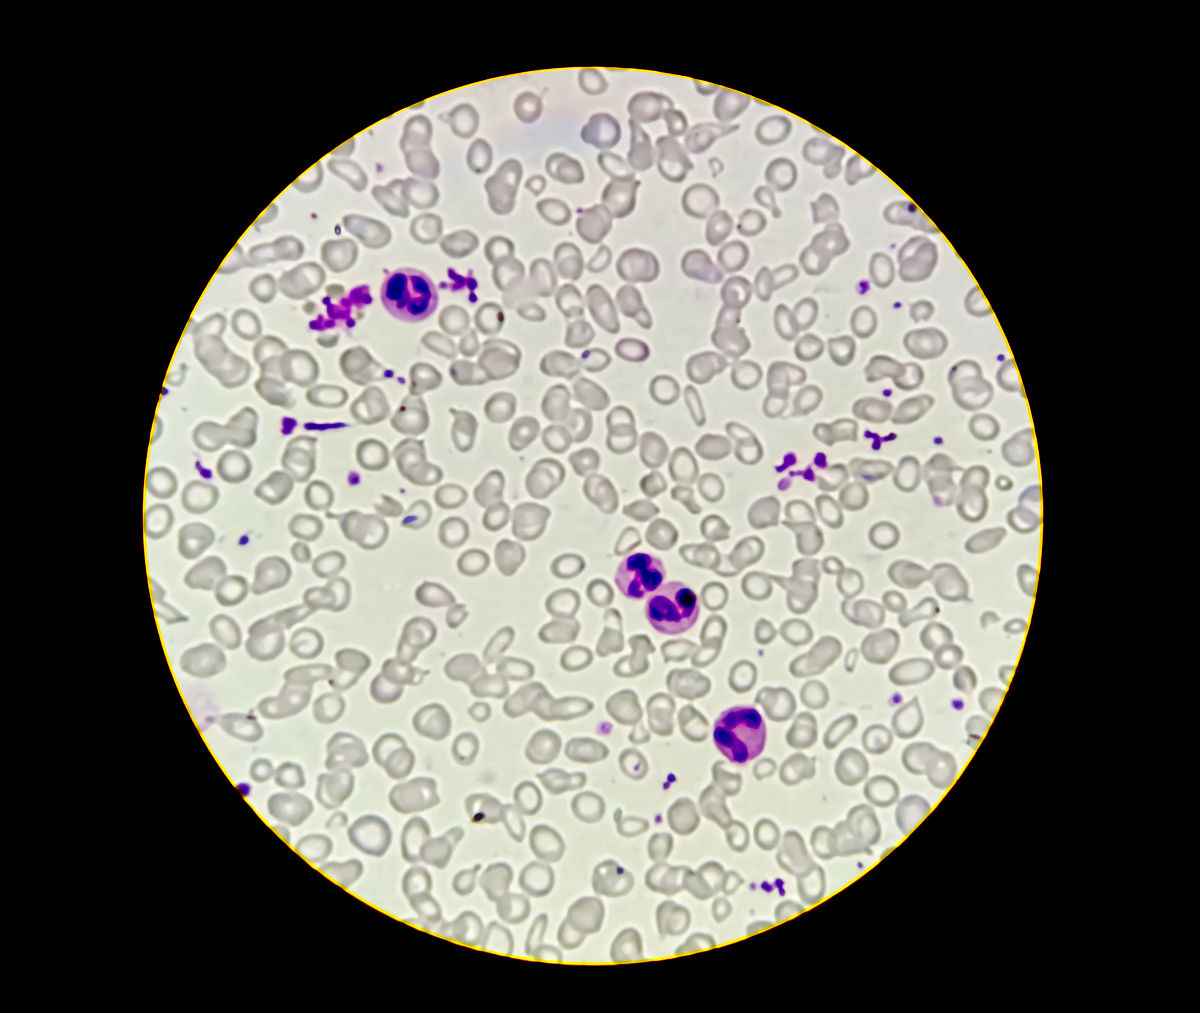
医学检验中血液细胞检验的质量控制影响因素

医学检验中血液细胞检验的质量控制影响因素
医学检验中血液细胞检验的质量控制影响因素
引言: 血液细胞检验在临床医学中起着至关重要的作用,可以帮助医生诊断和监测多种疾病。然而,血液细胞检验的质量控制是确保准确诊断的关键因素。本文综述了一系列与血液细胞检验相关的文献,探讨了影响血液细胞检验质量控制的因素。
论述分析:
-
Gong X. The value of blood cell morphology test in the diagnosis of pediatric diseases[J]. Frontiers in Medical Science Research,2021,3.0(4.0). 这篇文章探讨了血细胞形态学检验在儿科疾病诊断中的价值。血细胞形态学检验可以通过观察血细胞的形态和结构来判断疾病的类型和程度,对于儿科疾病的早期诊断和治疗具有重要意义。
-
A L B,Henk S,C P L, et al. One third of alloantibodies in patients with sickle cell disease transfused with African blood are missed by the standard red blood cell test panel.[J]. Haematologica,2021. 该研究发现,在用非洲血液输血的镰状细胞病患者中,标准红细胞检验面板会漏掉约三分之一的异体抗体。这表明标准的红细胞检验方法可能存在一定的局限性,需要进一步改进和优化。
-
Lage A L A,Ribeiro M J,Souza-Fagundes D M E, et al. Efficient atrazine degradation catalyzed by manganese porphyrins: Determination of atrazine degradation products and their toxicity evaluation by human blood cells test models[J]. Journal of Hazardous Materials,2019,378. 这项研究评估了锰卟啉催化剂对阿特拉津的降解效率,并利用人体血细胞检验模型对降解产物的毒性进行了评估。这表明血细胞检验可以用于评估化学物质的毒性,为环境和健康风险评估提供参考。
-
M. R,M. H,E. N, et al. THE OXYGENSCAN: A COMPREHENSIBLE FUNCTIONAL RED BLOOD CELL TEST TO MONITOR TREATMENT EFFICACY IN PATIENTS WITH SICKLE CELL DISEASE:PS1523[J]. HemaSphere,2019,3. 该研究介绍了一种名为OXYGENSCAN的全面功能性红细胞检验,用于监测镰状细胞病患者的治疗效果。这种检验方法可以评估红细胞的功能状态,为镰状细胞病的治疗提供了重要的辅助指标。
-
Industry-Academic Cooperation Foundation Chosun University; Patent Issued for Morphological Cell Parameter-Based Red Blood Cell Test Method And Digital Holographic Microscope Used Therein (USPTO 10,241,469)[J]. Journal of Mathematics,2019. 该专利介绍了一种基于形态学细胞参数的红细胞检验方法,并使用数字全息显微镜进行观测。这种新的检验方法可以提供更准确和可靠的红细胞形态学分析,有助于提高血液细胞检验的质量。
-
Tang Y,Cai R,Cao D, et al. Photocatalytic production of hydroxyl radicals by commercial TiO2 nanoparticles and phototoxic hazard identification[J]. Toxicology,2018,406-407. 这项研究探讨了商业TiO2纳米颗粒的光催化产生羟基自由基的能力,并对其光毒性进行了评估。血细胞检验在评估化学物质的光毒性中发挥了重要作用,为毒性评估和安全使用提供了依据。
-
Erythroid Cells - Erythrocytes; Researchers Submit Patent Application, 'Morphological Cell Parameter-Based Red Blood Cell Test Method and Digital Holographic Microscope Used Therein', for Approval (USPTO 20170357211)[J]. Journal of Mathematics,2018. 该专利介绍了一种新的红细胞检验方法,并使用数字全息显微镜进行观测。这种新的检验方法可以提供更准确和可靠的红细胞形态学分析,有助于提高血液细胞检验的质量。
-
Pape J W,Maurer T,Pfannenbecker U, et al. The Red Blood Cell Phototoxicity Test (Photohaemolysis and Haemoglobin Oxidation): EU/COLIPA Validation Programme on Phototoxicity (Phase II)[J]. Alternatives to Laboratory Animals,2001,29(2). 该研究介绍了一种红细胞光毒性检验方法,用于评估化学物质的光毒性。该方法在欧盟和COLIPA的验证计划中被认可,为化妆品等产品的安全使用提供了重要的参考。
-
Pape W,Pfannenbecker U,Argembeaux H, et al. COLIPA validation project on in vitro eye irritation tests for cosmetic ingredients and finished products (phase I): the red blood cell test for the estimation of acute eye irritation potentials. Present status[J]. Toxicology in Vitro,1999,13(2). 该研究介绍了一种红细胞检验方法,用于评估化妆品成分和产品的急性眼刺激性。该方法在COLIPA的验证计划中被认可,为化妆品等产品的安全使用提供了重要的参考。
-
J W P,U H. Standardization of an in vitro red blood cell test for evaluating the acute cytotoxic potential of tensides.[J]. Arzneimittel-Forschung,1990,40(4). 该研究介绍了一种标准化的体外红细胞检验方法,用于评估表面活性剂的急性细胞毒性。该方法为表面活性剂等化学物质的安全使用提供了重要的参考。
结论: 综上所述,血液细胞检验在医学诊断和毒性评估中具有重要作用。然而,标准方法存在局限性,需要进一步改进和优化。新的检验方法和技术的引入将有助于提高血液细胞检验的准确性和可靠性。此外,血液细胞检验的应用范围还可以扩展到其他领域,如环境毒性评估和治疗效果监测等。在未来的研究中,我们应该继续关注血液细胞检验的质量控制,以提高临床诊断的准确性和可靠性。
原文地址: https://www.cveoy.top/t/topic/fNb0 著作权归作者所有。请勿转载和采集!